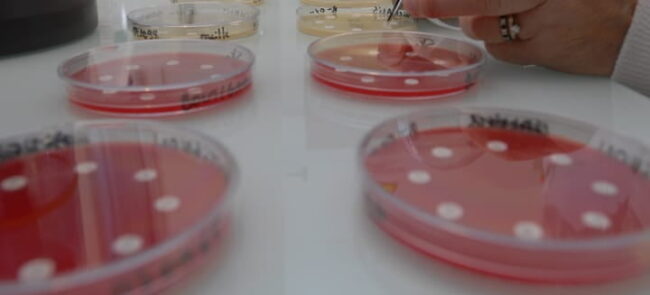

Peut-on entraîner un lapin à faire ses besoins dans sa caisse ?
Oui c’est possible, le lapin est souvent naturellement propre. Laissez-le dans un premier temps enfermé dans sa cage, de façon à ce qu’il en élise un coin comme toilettes. Au bout d’une dizaine de jours, enlevez le couvercle de sa cage et laissez-le déambuler dans la pièce. Il y a de fortes chances qu’il retourne…